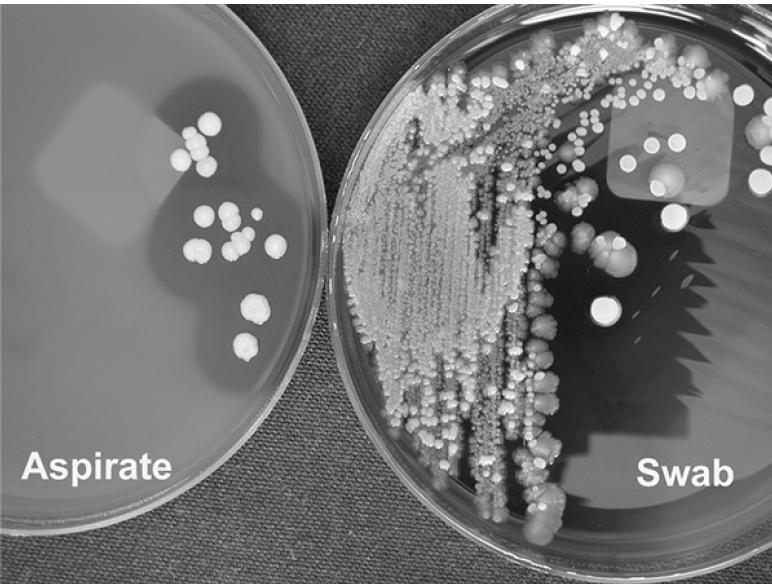
- Comparison of aspirated pus and swab culture from an infected joint site. Image source: Koneman’s Color Atlas and Textbook of Diagnostic Microbiology

Skin is the body’s largest and thinnest organ which serves as an anatomical barrier between the sterile internal organs and the external environment, which is teemed with microorganisms. Break in the skin surface may result in skin and soft tissue infections. Wound infection can also occur as a complication of surgery, trauma, and bites or diseases that interrupt mucosal or skin surfaces.
Wound infections may be caused by one or many organisms depending on the site of the infection. For example, dermatophytes are responsible for infections in the keratinized layer; superficial skin wounds are often caused by aerobes only, while anaerobes are commonly isolated from abscesses of the perineal, inguinal, and buttock area, whereas mixed facultative aerobic organisms cause non-perineal infections. Similarly, postoperative wounds are often infected with a mixture of aerobes and anaerobes. In contrast, deep wound infections, such as internal body or organ infections, can be caused by one or several aerobes and/or anaerobes.
Abscesses are accumulations of pus in tissue and any organism isolated from them may be of significance.
Wounds, especially postoperative wounds, may become colonized with potential pathogens. A gram stain is a useful diagnostic tool in determining colonization versus infection. A gram stain showing few or no polymorphonuclear cells with relatively large amounts of normal skin flora are consistent with colonization. However, wound gram stains showing moderate to many polymorphonuclear cells usually indicate infection.
Possible pathogens in Pus
**NOTE:**This blog post contains information ONLYabout the isolation and identification of common bacterial isolates (aerobes and facultative anaerobes) from pus aspirate/swab.
| Gram-positive | Gram-negative |
|---|---|
| Staphylococcus aureus | Pseudomonas aeruginosa |
| Streptococcus pyogenes | Escherichia coli |
| Enterococcus species | P roteus species |
| Anaerobic streptococci | Klebsiella species |
| Other streptococci | Bacteriodes species |
| Clostridium perfringens and other clostridia | Acinetobacter species |
| Actinomycetes | Other enteric bacilli |
| Mycobacterium tuberculosis | |
| Others | |
| Fungi: Histoplsama , Candida, and fungi that cause mycetoma. | |
| Parasites: Entamoeba histolytica (in pus aspirated from an amoebic liver abscess) | |
| Viruses: Pox viruses and herpes viruses |
Specimen Collection
As far as possible, collect specimens before antimicrobial therapy and/or before applying the antiseptic dressing. The ideal specimen is an aspirate from a previously undrained abscess or a tissue biopsy. Ideally, a minimum volume of 1mL (up to 5 mL) of pus should be collected. Large volumes of purulent material maintain the viability of anaerobes for longer.
The aspirate should be collected in a sterile syringe – any air bubbles should be expelled. Needle safely and tightly capped (needles should NOT be sent).
A tissue specimen should be placed in a sterile universal bottle (or any sterile leakproof container) and sent to the lab for immediate processing if anaerobes are suspected. If there is a delay in transporting, the tissue should be placed in an anaerobic transport system.
Swabs are less desirable because of the smaller amount of sample specimen and the fact that they are often contaminated with normal skin flora, making interpretation of results difficult. When using swabs, the deepest part of the wound should be sampled, avoiding the superficial microflora. Swabs should be well soaked in pus.
Specimen Transport
Label the specimen and deliver it to the laboratory as soon as possible with a completed request form. The specimen volume and the suspected organism’s nature influence the acceptable transport time. The recovery of anaerobes is compromised if the transport time exceeds 3hr. Suppose delays in transportation to the laboratory are unavoidable. In that case, samples should be placed in the transport medium (Amies transport medium or Cary-Blair transport medium) to minimize drying and exposure to oxygen if anaerobes are suspected.
If processing is delayed, refrigeration is preferable to storage at ambient temperature.
Laboratory examination of Pus sample
- Describe the appearance of the specimen: Describe the presence or absence of sulfur granules (needed only for the suspected cases ofmycetomaor actinomycosis, when requested).
- Preparation of the Smear
- If pus swab is sent:
Only one aerobic pus swab: Inoculate the culture media first before using the swab to make smears for Gram staining If swabs (one anaerobic and two aerobic) are submitted for culture, use the second swab to make gram stain
- If tissue sample is submitted: make a Gram stain from ground tissue.
- If pus aspirate is sent, place one drop of pus onto a clean microscope slide using a sterile pipette. Spread this using a sterile loop to make a thin smear for Gram staining.
- Gram Staining: Make an evenly spread smear of the specimen on a clean, grease-free slide. Allow the smear to air-dry in a safe place. Heat fix the specimen and stain by Gram staining technique. Examine the smear for the presence of bacteria and pus cells (PMNs) using 100x objective lens and look especially for:
Gram-negative rods (possible pathogens are E.coli, Klebsiella pneumoniae,Pseudomonas aeruginosa, Proteus or Bacteroides species) Gram-positive cocciin pairs, chains or clusters (possible pathogens are *Staphylococcus aureus,Streptococcuspyogenes,*anaerobic streptococci or enterococci). Gram positive large rods with square ends (possible pathogens are Clostridium perfringens or Bacillus anthracis) In the case of anaerobic infections large number of pleomorphic bacteria (streptococci, Gram positive and Gram negative rods of various sizes and fusiform bacteria) may be seen. Sometimes, Gram-positive yeast cells with pseudohyphae may be seen, which can beCandida albicans.

Pus Culture
**Culture Media:**Wound specimens collected on aerobic swabs or pus aspirate should be plated on to the following media:
- Sheep blood agar(to isolate S. aureus and Streptococcus**pyogenes or other streptococci)
- MacConkey agar (to isolate Gram-negative rods)
Incubation Condition:
- Temperature: 35ºC -37ºC
- Atmosphere: Blood Agar plate in carbon dioxide enriched atmosphere (e.g. 5% CO2 incubator or in a candle jar) and MacConkey agar plate in ambient air (normal incubator)
- Time:Â Up to 48 hours (observe the plate after 24 hours of incubation, if growth is seen, do further processing, if not, reincubate for additional 24 hours.)
Examination and Reporting the Culture results
If the growth is seen after 24/48 hours of culture, the colony morphology and identification of the isolates should be examined.
In the Blood Agar plate, look for hemolysis. Staphylococus aureusand Streptococcus pyogenesgive beta-hemolysis in Blood Agar (Some S. aureus isolates may not show hemolysis).
- S. aureus gives yellow to cream or white colonies. Colonies are slightly raised and easily emulsified.
- S.pyogenes produces beta-hemolytic colonies. Colonies are usually small, colorless, dry, shiny, or mucoid.
- Enterococci give non-hemolytic colonies in blood agar.Â
We can differentiate between streptococci and staphylococci by a very simple and rapid test-Catalase test (Staphylococcus-positive, Streptococcus-negative). For identification of suspected S. aureus colonies, perform coagulase test(to differentiate coagulase-negative Staphylococci from S. aureus) and for suspected Group A Streptococci (S.pyogenes) perform bacitracin sensitivity test (can be added in the blood agar plate with other antibiotics). If enterococci is suspected perform bile esculin test.
Look for the growth of lactose fermenter colonies (pink) or non-lactose fermenter colonies (pale) in the MacConkey Agar plate. Lactose fermenter colonies can be of Escherichia coli, Klebsiella spps, or Enterobacterspps and non-lactose fermenter colonies can be of Psuedomonas aeruginosa, Acinetobacter spp, Proteus spps etc.Â

Member of the family Enterobacteriaceae can be differentiated from other Gram-negative bacilli by performing two rapid tests (catalase test +ve, and oxidase test –ve). Identifications of the enteric bacteria can be done by using biochemical tests such as citrate utilization test, Triple Sugar Iron (TSI) Agar test, Sulphite-Indole-Motility (SIM) test, and urease test.
Pseudomonas aeruginosa gives large, flat, spreading pale-colored colonies in MacConkey Agar. It is oxidase positive and can be identified by its pigments and/or distinctive smell (characteristics of fruity smell).
Depending on the facilities available in the diagnostic laboratories, organisms can be identified using enterotube test or API-20E test or other newer diagnostics tests available for identifying isolates.
Antimicrobial Sensitivity Testing
For Streptococcus pyogenes and Enterococci, antimicrobial sensitivity testing should be done in MHA supplemented with sheep blood. For S.aureus and other gram-negative bacilli, Mueller-Hinton Agar (MHA)is used. The selection of the antibiotics panel depends on the isolated organism. Unless indicated routinely used (or first line), antibiotics should be used. If the patient is in an intensive care unit (SICU, PICU, NICU) or is receiving particular antibiotic, or the isolate is resistant to first-line antibiotics, sensitivity testing should include requested antibiotics and/or second-line antibiotics.
References and further reading
- Color Atlas and Textbook of Diagnostic Microbiology, Koneman, 5th edition
- Bailey & Scott’s Diagnostic Microbiology, Forbes, 11th edition
- District Laboratory Practice in Tropical Countries Part-2. Monica Cheesbrough, 2nd edition